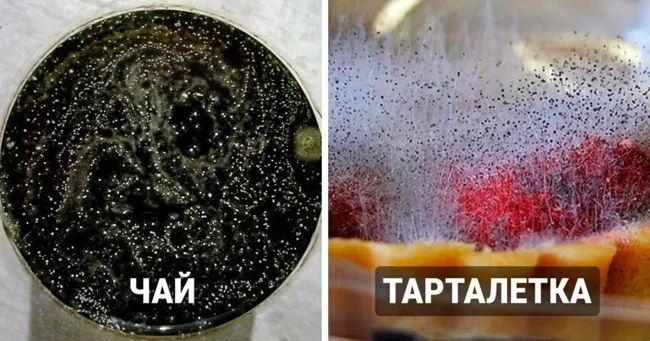
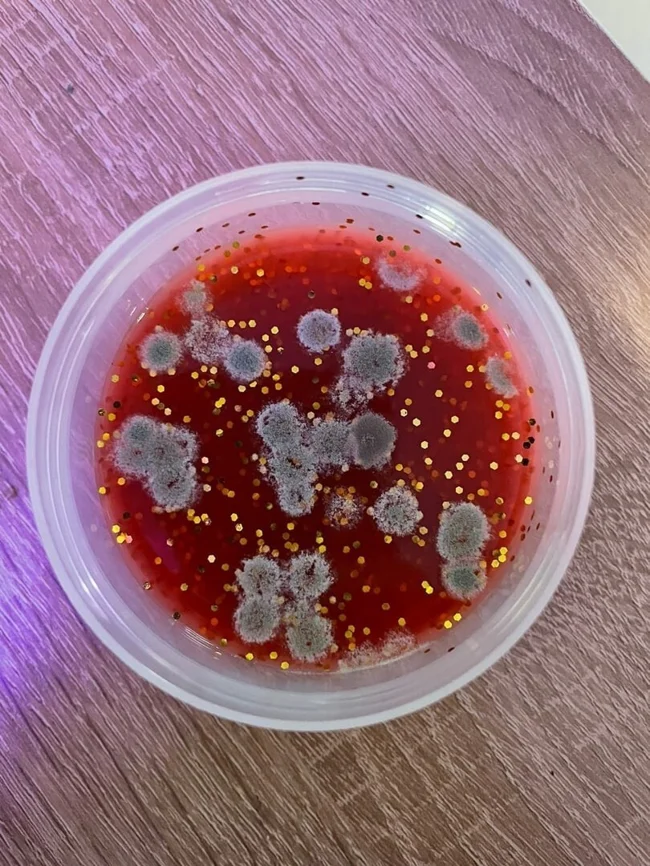

14 удивительных снимков, показывающих, насколько разнообразной может быть плесень (15 фото)
Плесень тоже умеет создавать настоящие произведения искусства, и старательные люди-забываки это доказали.
Многие, услышав слово грибы, сразу же представляют себе подберёзовики, лисички или мухоморы. Но мало кто вспоминает о том, что плесень — это тоже грибы, чьё разнообразие достаточно велико. В этом легко убедиться, если забыть про какой-то продукт на некоторое время. Ведь под воздействием окружающей среды еда может преобразиться до неузнаваемости, знатно удивив своего забывчивого хозяина. Здесь и космический чай, и пыльные дюны от сыра, и даже варёное яичко на хлебушке.
Когда-то это был чай 
А теперь это космос.
Вишня в сиропе 
Лимон, который месяц пробыл в холодильнике 
Свёкла 
Спагетти Болоньезе 
Полгода назад мама сделала мне болонезе в дорогу. Полгода спустя этот болонезе уже не болонезе.
Нейронные связи в квасе 
Батон 
Плесень-антистресс в бражке 
Так и хочется все эти пузырики скорее полопать.
Консервированный ананас 
Тарталетка 
Пирог просто переквалифицировался из ягодного в грибной.
Пыльные дюны сыра фета 
Лизун решил, что ему мало блёсток, поэтому он добавил ещё
Вода из-под зелёного горошка 
Ну что за морской прибой на песчаном пляже? Ляпота и только!
А ещё знатоки веганской кухни отметили, что оставшуюся воду от бобовых часто используют как заменитель белка. В результате из этого творения можно сделать псевдозефир, безе, майонез или просто добавить в тесто. Получается очень даже вкусно!
Кусочек хлебушка 
Я случайно вырастила варёное яичко на хлебушке.





